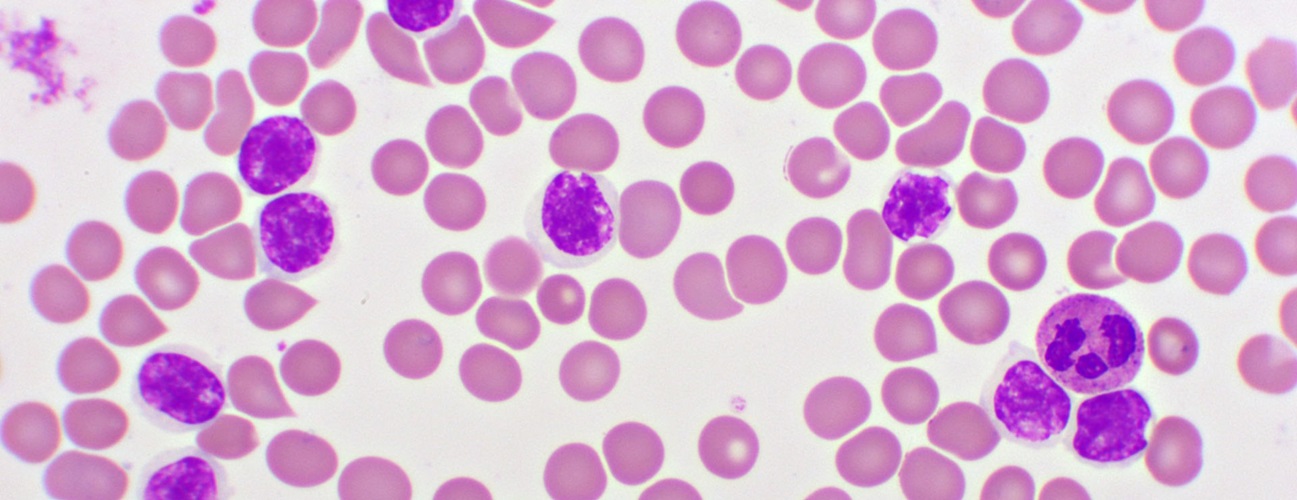
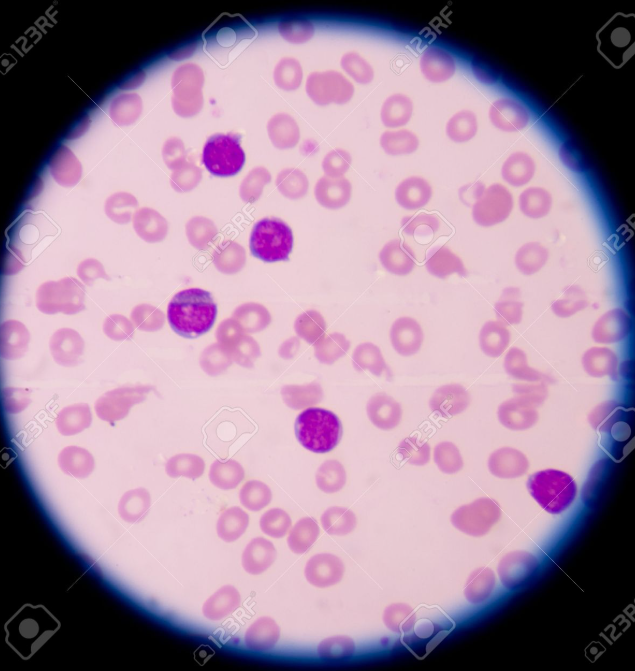

흔히 백혈병, 백혈병이라고 하면,
급성 림프구성 백혈병(Acute lymphocytic leukemia),
즉, 급성림프모구백혈병(Acute lymphoblastic leukemia) 를 의미합니다.

약어로는 ALL 이라불리는 이 질환은, 소아 악성 종양 중 발생률이 가장 높은 혈액암입니다.
골수에서 비정상적인 림프모구(lymphoblast)로 인해 미성숙 림프구(lymphocyte)가 비정상적으로 증식하여
정상 조혈 기능을 억제하고, 전신 장기에 침범해 다양한 증상을 유발합니다.
림프구성 백혈병의 주요 증상은,
조혈기능 억제로 인한 증상입니다.
적혈구 생성의 장애로 인해, 빈혈이 발생하면, 창백, 무기력, 피로 등이 나타나며,
혈소판 감소로 인해서는 멍, 점막출혈, 코피(50%에서 관찰)등이 발생합니다.
정상적인 기능을백혈구 감소로 인해 발열(25%에서 발생), 감염 빈도 증가 등입니다.
장기의 변화도 나타나는데,
비장비대, 간비대, 림프절 종대소견이 관찰됩니다.
그외에, 뼈·관절 침범 이 있는 경우, 뼈 통증, 관절통이 발생하고,
중추신경계 침범 (5~10%) 이 있는 경우,
두통, 구토, 시력저하, 뇌수막염 유사 증상(경부강직 등) 이 가능합니다
진단을 위한 검사에는
기본적인 검사로, 말초혈액도말(PBS)를 통해
빈혈, 과립구 감소, 혈소판 감소, 백혈병 세포등을 확인할 수 있습니다.
흉부 X선 영상촬영을 통해 종격동 종괴 여부 확인해야하는데,
이는 특히 T-cell ALL에서 흔하게 발생합니다.
그외 특수 검사로,
뇌척수액(CSF) 검사를 통해 CNS 침범 여부 확인이 필요하고,
골수검사를 통해
백혈병 세포의 형태 확인을 통해
골수아세포 ≥ 20% 이면 급성 백혈병 확진 (WHO 기준)이 가능합니다.

'소아 혈액질환' 카테고리의 다른 글
| 호지킨 림프종 (Hodgkin lymphoma) – 림프절에 발생한 암 (0) | 2025.09.03 |
|---|---|
| 급성 림프구성 백혈병(ALL) – 치료, 재발, 예후 인자 항암치료 방사선치료 약물 (0) | 2025.09.03 |
| 소아암 개관 – 발생 빈도와 동종 조혈모세포 이식 대상 질환 (1) | 2025.08.14 |
| 골수검사(Bone marrow biopsy) 나이 연령별 부위 선택 골수천자 (4) | 2025.08.08 |
댓글